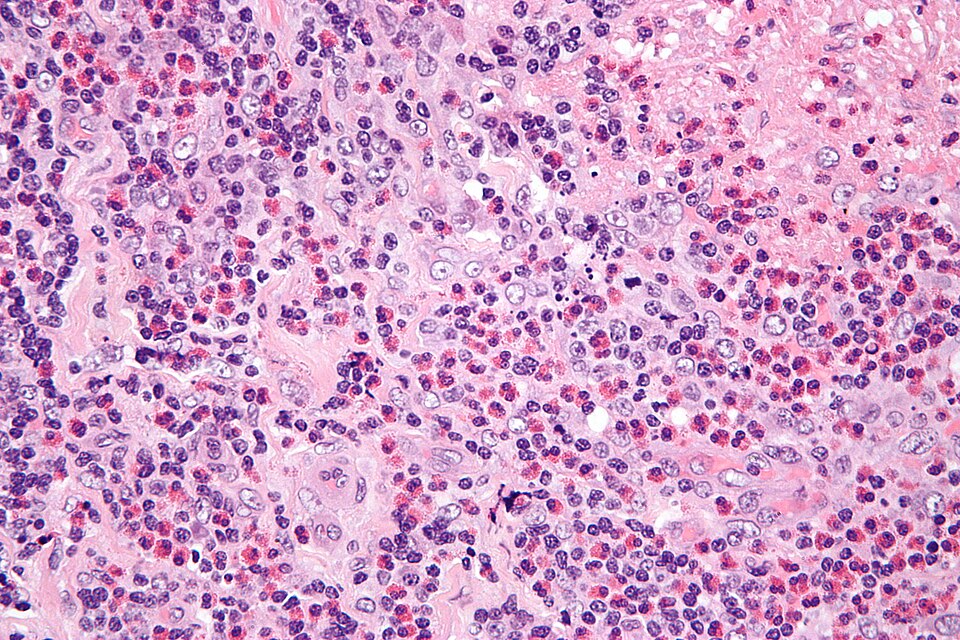
File:Kimura disease - very high mag.jpg

File:Kimura disease - very high mag.jpg
Jump to navigation
Jump to search

Size of this preview: 800 × 533 pixels. Other resolutions: 2,560 × 1,707 pixels | 4,272 × 2,848 pixels.
Original file (4,272 × 2,848 pixels, file size: 5.99 MB, MIME type: image/jpeg)
File history
Click on a date/time to view the file as it appeared at that time.
| Date/Time | Thumbnail | Dimensions | User | Comment | |
|---|---|---|---|---|---|
| current | 04:26, 10 August 2010 |  | 4,272 × 2,848 (5.99 MB) | Nephron | {{Information |Description={{en|1=Very high magnification micrograph of '''Kimura disease''', also '''Kimura lymphadenopathy''' and '''Kimura's disease'''. H&E stain. Features: *Thick-walled blood ves |
File usage
The following 2 pages use this file:
